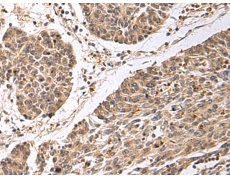
一抗

中文名稱:兔抗CD24多克隆抗體
英文名稱: Anti-CD24 rabbit polyclonal antibody
相關類別: 一抗
儲 存: 冷凍(-20℃)
宿 主: Rabbit
反應種屬: Human
克隆類型: rabbit polyclonal
|
Background: |
This gene encodes a sialoglycoprotein that is expressed on mature granulocytes and B cells and modulates growth and differentiation signals to these cells. The precursor protein is cleaved to a short 32 amino acid mature peptide which is anchored via a glycosyl phosphatidylinositol (GPI) link to the cell surface. This gene was missing from previous genome assemblies, but is properly located on chromosome 6. Non-transcribed pseudogenes have been designated on chromosomes 1, 15, 20, and Y. Alternative splicing results in multiple transcript variants. |
|
Applications: |
ELISA, IHC |
|
Name of antibody: |
CD24 |
|
Immunogen: |
Synthetic peptide of human CD24 |
|
Full name: |
CD24 molecule |
|
Synonyms: |
CD24A |
|
SwissProt: |
P25063 |
|
ELISA Recommended dilution: |
5000-10000 |
|
IHC positive control: |
Human colorectal cancer |
|
IHC Recommend dilution: |
50-100 |


 購物車
購物車 幫助
幫助
 021-54845833/15800441009
021-54845833/15800441009